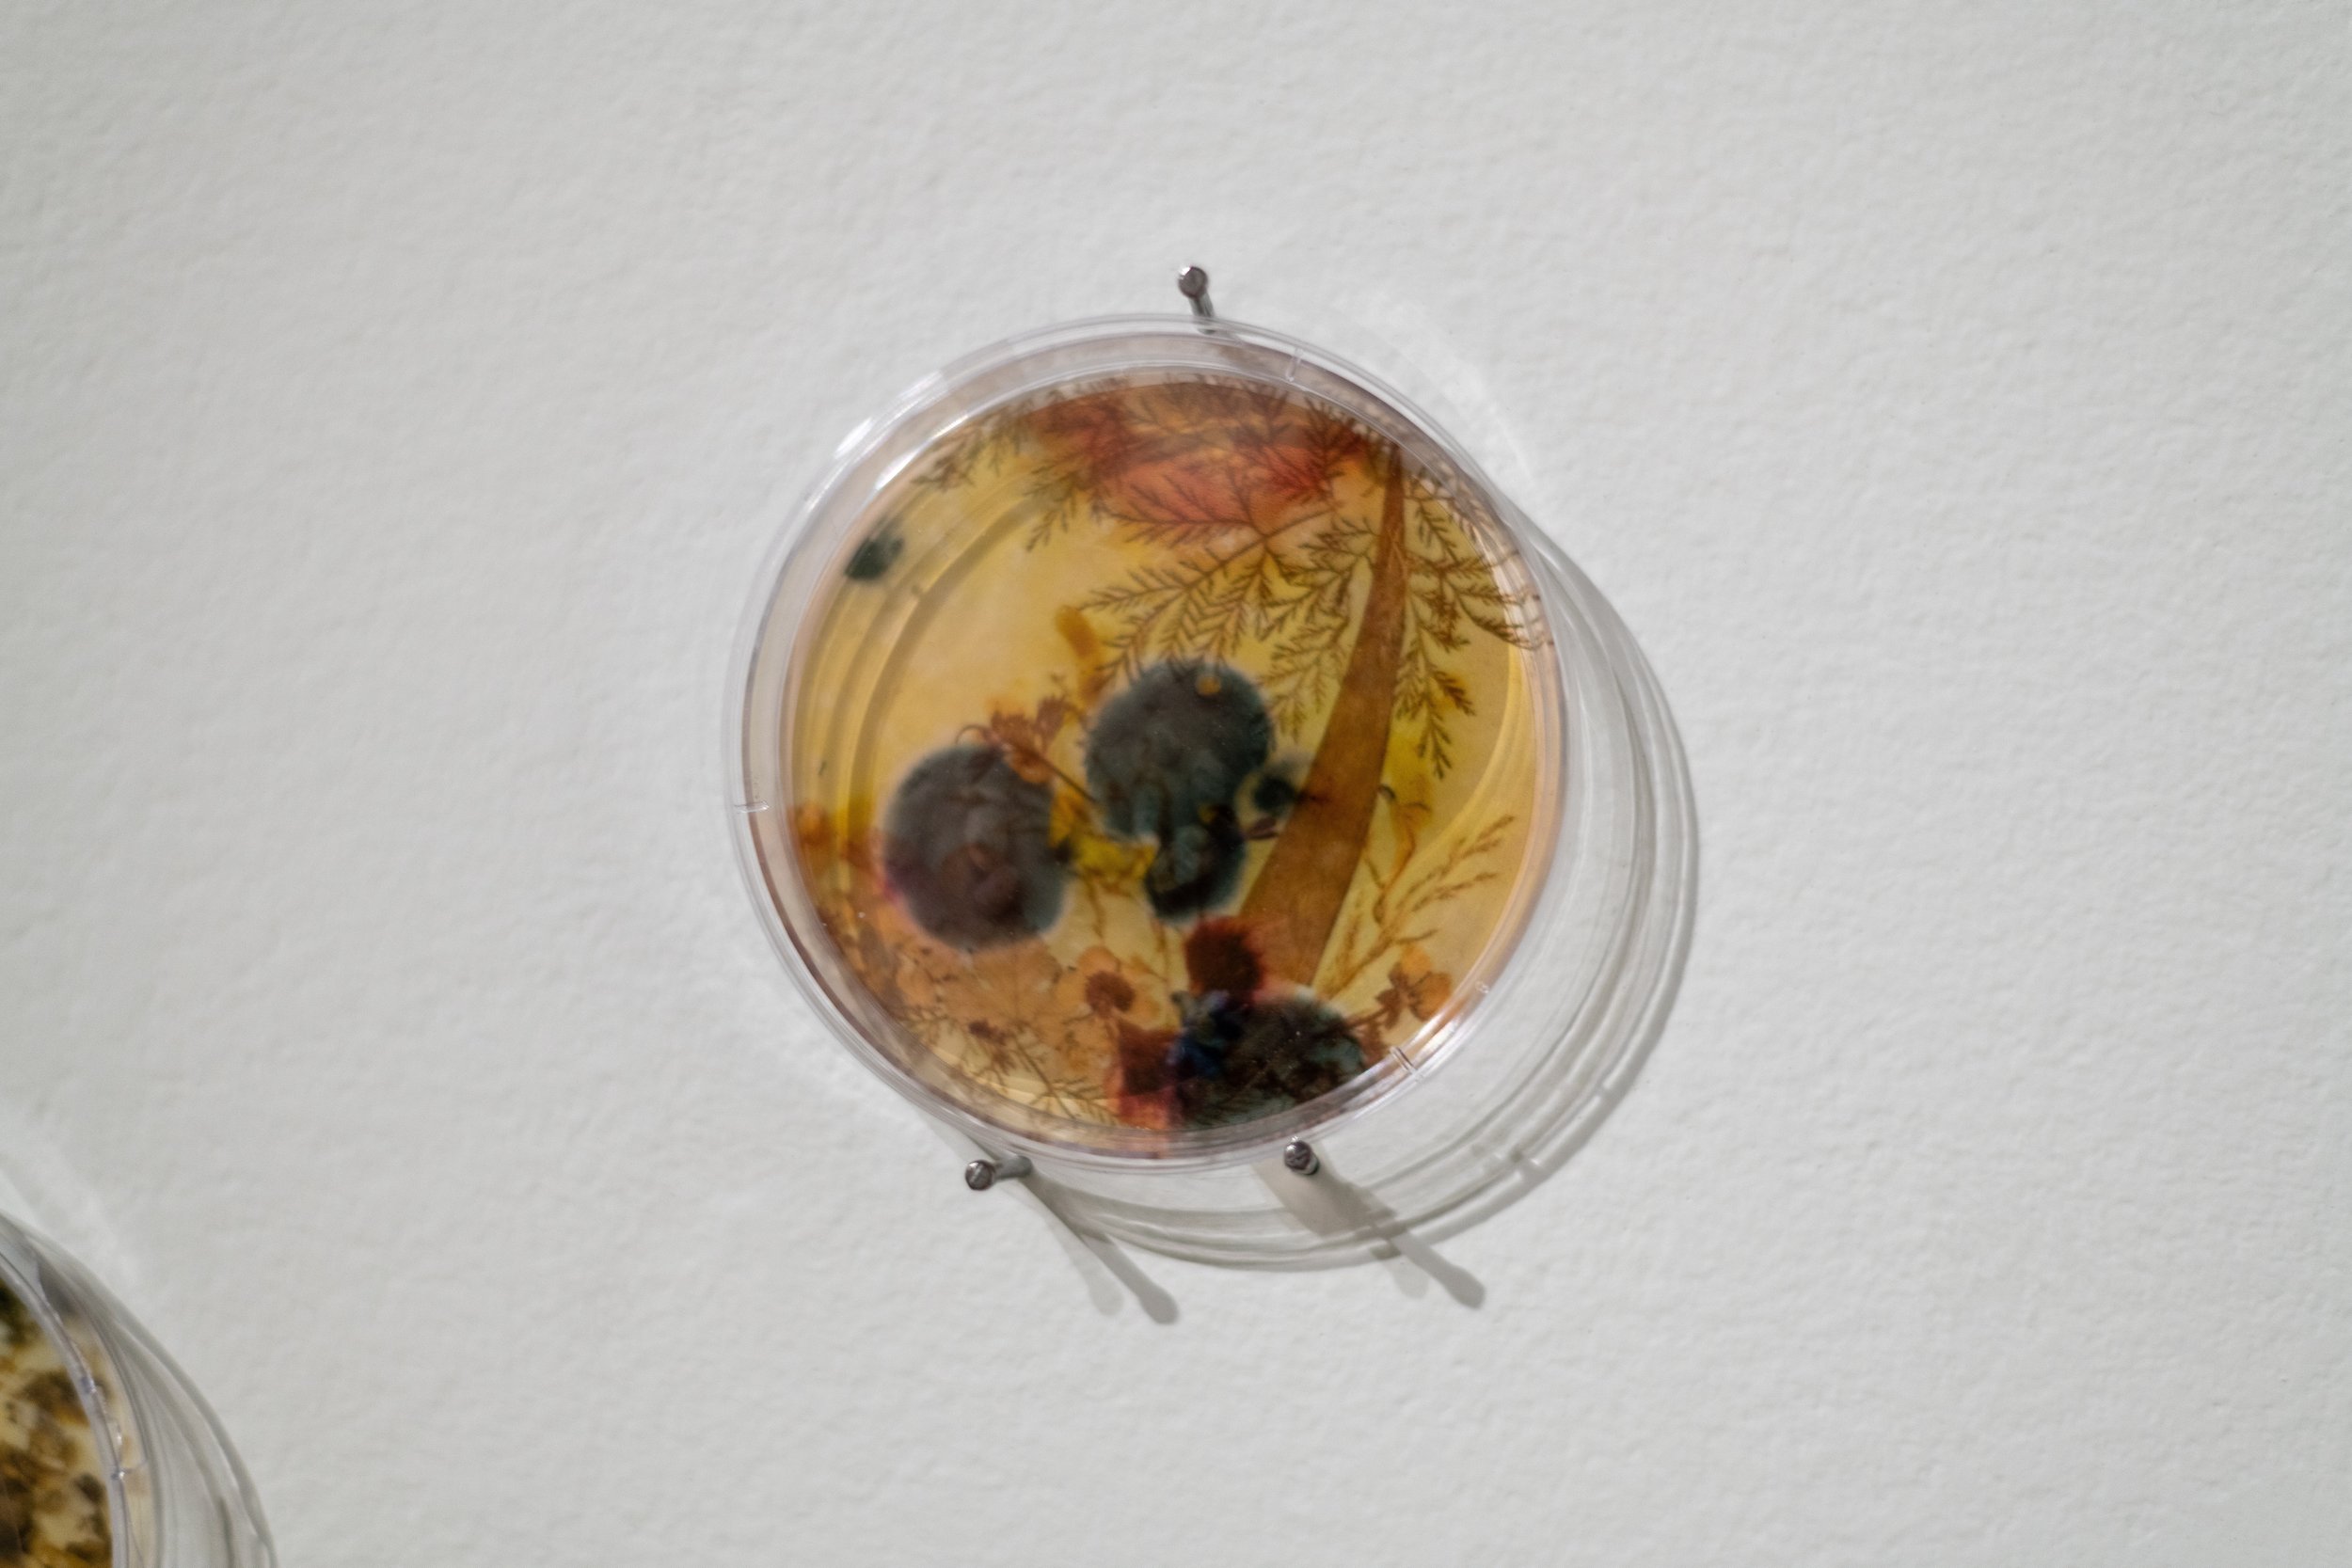
DSC_4955.jpeg
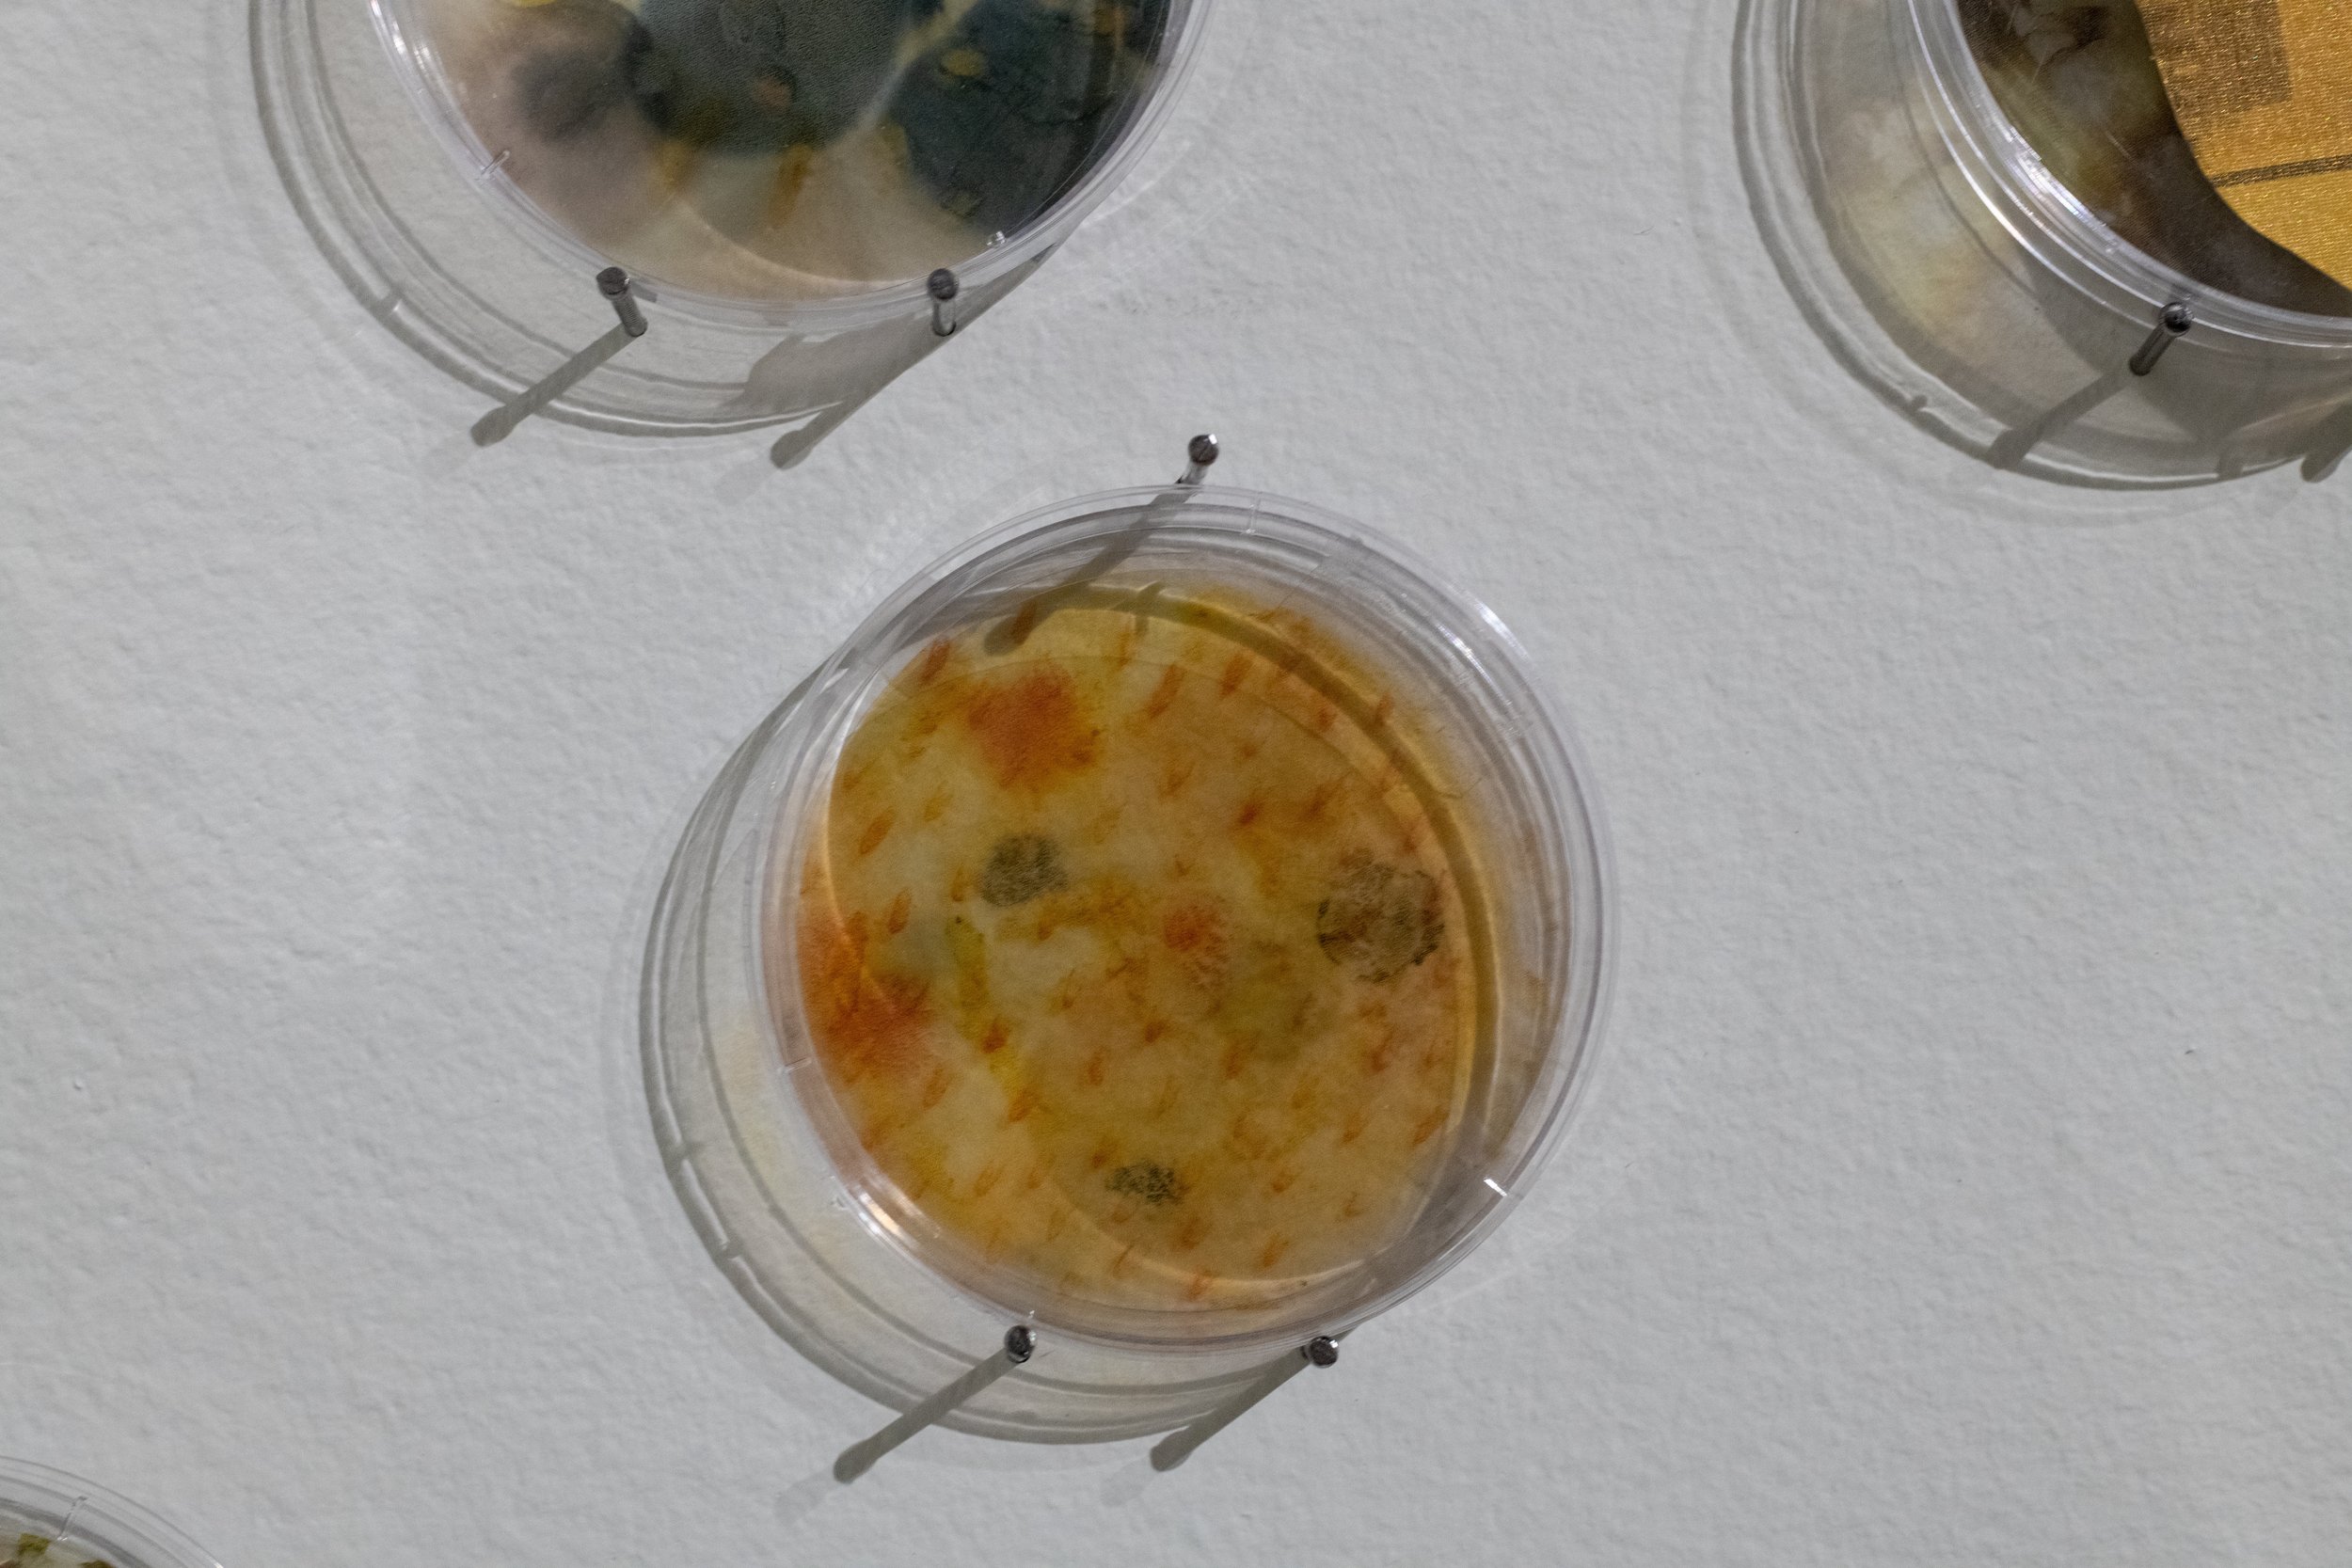
DSC_4990.jpeg

Hunā wa hunāk (here and there) | هنا و هناك
Jude Abu Zaineh
Petri dishes, digital prints
15’ x 18’
2022
Hunā wa hunāk (here and there) |هنا و هناك is a cluster of petri dishes featuring family album photographs, layered with images of food, flowers, and plants from South West Asia and North Africa. These photographs were shared by individuals in Windsor-Essex and beyond whose ancestry is from this broad region. With this work, the artist points to multiple diasporas, and invites the community to see themselves and their migratory experiences reflected back. The use of petri dishes, and the images of mould, reference cycles of growth and decay in which fungal cultures grow and transform the enclosed environment. For the artist, the evolution of organisms in new environments is symbolic of the hybrid cultural traditions that emerge in diasporic individuals as a response to having dual identities.
Installation shot from solo exhibition, In the Presence of Absence, curated by Noor Ale; Art Windsor-Essex. Photos by Michael Valiquette, Frank Piccolo.